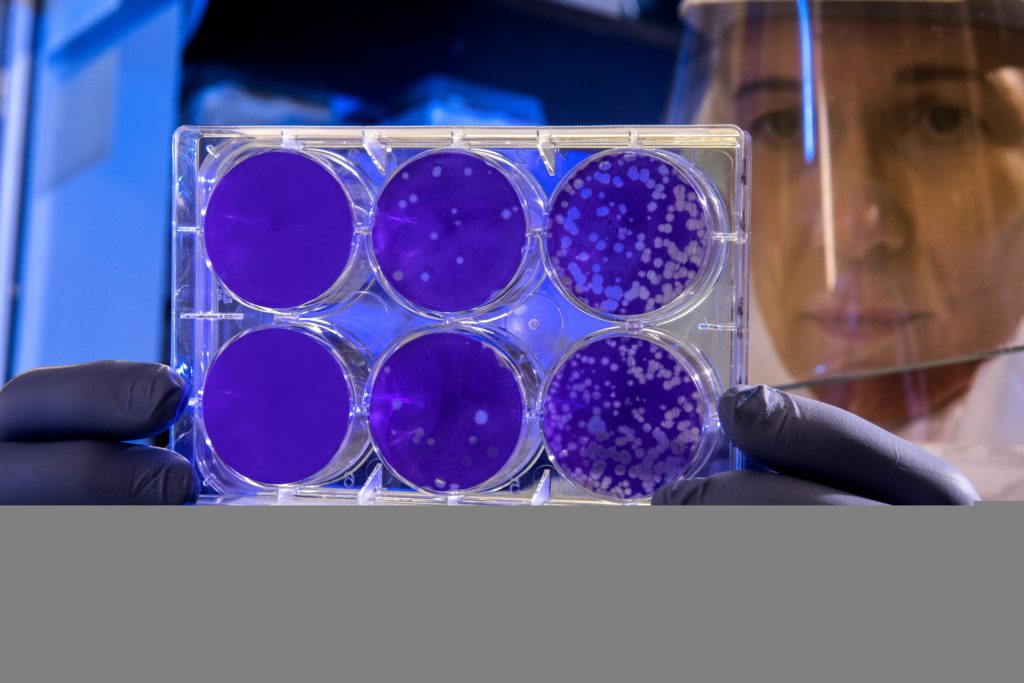

Le coronavirus n’est pas mortel sur les individus en pleine forme. Ce sont sur les individus ayant d’autres faiblesses que le coronavirus peut être mortel. Les faiblesses en question peuvent être une hépatite, un diabète ou tout autre.
En fait, être robuste et en pleine forme, c’est l’antidote contre les virus et le coronavirus. Autrement dit, ces hommes en pleine forme ne meurent pas, même s’ils en sont atteints. Et j’aurais tendance à dire qu’ils ne seront même pas atteints car leur système immunitaire dévorera le virus.
Quel lien faut-il tirer de cette pandémie ? Exploiter l’antidote en se protégeant soi-même des autres maladies, est une bonne solution.
Ce sont ces maladies-là que je propose d’éradiquer. Ce sont des maladies dues aux mutations naturelles cycliques extérieures au corps humain. On peut donc les éradiquer sans avoir à prendre ou ingurgiter des médicaments.
Ces maladies que je propose d’éradiquer commencent dès la naissance et détruisent notre système immunitaire. Ce système est conçu pour chasser ou détruire un intrus mais il n’est pas prévu pour des légions simultanées d’intrus. Notre corps n’est pas armé face à ces légions.
Le combat que je mène par ma découverte, c’est de fermer la porte aux intrus tant extérieurs qu’intérieurs au corps, « urbi et orbi ». C’est comme dans toute chose, que ce soit en économie comme au naturel : avant de livrer bataille, il faut regarder les forces en présence.
Un homme robuste est bien plus armé qu’un homme faible. C’est pourquoi, d’ailleurs, les fonds de pension, qui proviennent de surcroît des retraites, ne s’adressent qu’aux entreprises en état de faiblesse parce qu’ils y sont mieux armés.
Bien sûr, il est utile de combattre la faiblesse mais ne serait-il pas plus intelligent de l’empêcher de rentrer dans notre corps ? Sinon, chaque année, nous retrouverons les mêmes problèmes ; que ce soit la grippe, que ce soit la gastro, ce n’est pas le fait du hasard. Tous ces virus ne s’attaquent qu’aux faibles ou pour le moins ne sont pas neutralisés chez les faibles.
Ce que je propose, c’est une autre vie, un nouveau monde où la puissance de chacun pourra faire face à tous les intrus et mieux encore ne laissera pas de place à la destruction du corps, que ce soit les stigmates de la vieillesse ou les souffrances d’un cancer ou encore d’une grande maladie terrible, Alzheimer, Parkinson, où l’homme se voit diminué et meurt au combat.





